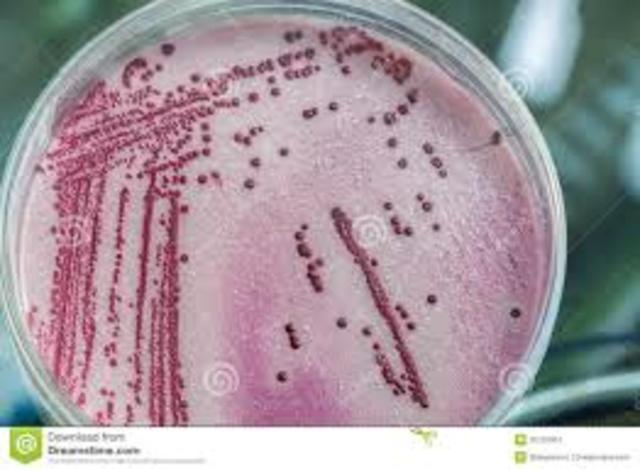
Teoria de la biogénesis. John Tyndall
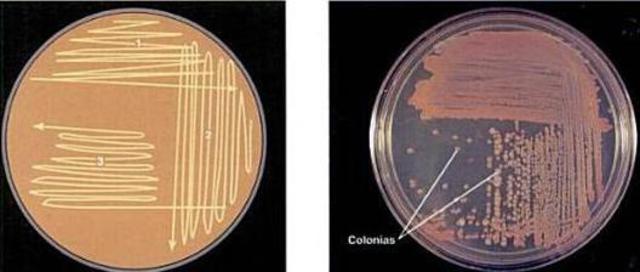
Método de enriquecimiento de cultivos.

-
Un microscopio compuesto tiene más de un lente objetiva. Los microscopios compuestos sirven especialmente para examinar objetos transparentes, o cortados en láminas tan finas que se transparentan. Se emplea para aumentar o ampliar las imágenes de objetos y organismos no visibles a simple vista
-
La palabra "célula" fue usada por primera vez en sentido biológico por el científico inglés Robert Hooke (1635-1701). Con un microscopio que él mismo fabricó, notó que el corcho y otros tejidos vegetales están constituidos por pequeñas cavidades separadas por paredes.
-
En el siglo XVII, (1668) demostró que los
gusanos encontrados en la carne podrida
eran las larvas que provenían de los
huevos que previamente habían
depositado en la carne las moscas y no el
producto de la generación espontánea. -
Pionero en el descubrimiento de los glóbulos rojos, los espermatozoides, las bacterias y los ciclos vitales de los insectos.
También confirmó y desarrolló el descubrimiento de la red de capilares del italiano Marcello Malpighi. -
Carl Linnaeus. creó un sistema de nomenclatura binomial para clasificar a los seres vivos. Fue quien agrupó los generos en familias, estas en clases y las clases en reinos.
-
Lazzaro Spallanzani. En ampollas de vidrio selladas pone tejidos en descomposición previamente esterilizados con calor. Pero esta vez hierve por más tiempo los caldos nutritivos: de esta forma eliminó la posibilidad del surgimiento espontáneo de microorganismos. Lo refuta y hace notar que la fuerza vegetativa persiste, pues al exponer los caldos al aire libre, los gérmenes se desarrollan sobre ellos.
-
Agostino Bassi. Demuestra que la enfermedad del gusano de seda es provocada por un hongo.describe una teoría que explica numerosas dolencias vegetales, animales y de humanos por organismos patogénicos. Refuerza así, la teoría de que las enfermedades contagiosas como variola, tifo exantemático, sífilis, cólera podrían tener origen microbiana.
-
Jenner tuvo la idea de inocular a una persona sana con la viruela de las vacas para conferirle inmunidad frente a la terrible enfermedad. Extrajo pus de una pústula de la mano de Sarah Nelmes, una ordeñadora que había contraído la viruela de su vaca lechera, y lo inoculó a un saludable niño de 8 años llamado James Phipps.
-
Theodor Schwann. Describió las células vegetales y propuso una teoría de la célula que estaba seguro que era la clave para la anatomía y el crecimiento de las plantas. Siguiendo esta línea de investigación sobre los tejidos animales, Schwann no sólo verificó la existencia de células, sino que trazó en el desarrollo de tejidos adultos de muchas de las etapas del embrión temprano.
-
Miles Joseph Berkeley descubre un hongo (Phytophthora infestans) que produce la podredumbre de la patata.
-
Propone la utilización de antisépticos para evitar la fiebre puerperal.la forma clínica específica de la infección, tal como endometritis—inflamación del revestimiento interior del útero—, flebotrombosis—inflamación de las venas del útero—, y la peritonitis o inflamación de la membrana de revestimiento del abdomen.
-
John Snow realiza el primer estudio epidemiológico del cólera en Londres. Más del 70% de las muertes por cólera durante el brote de 1854 se produjeron dentro de esta área de influencia, lo que reforzaba aún más si cabe la relación entre el agua contaminada y los casos de infección.
-
Desarrolló mediante calor la práctica quirúrgica de la asepsia y la antisepsia, mejorando notablemente la situación postoperatoria de los pacientes.Contribuyó a reducir en gran medida el número de muertes por infecciones contraidas en el quirófano después de que los pacientes fueran sometidos a intervenciones quirúrgicas.
-
Crea un taxón denominado Moneres para agrupar a las bacterias. Precursor de la división entre los seres procariotas y eucariotas.De esta manera Haeckel es un precursor de la división entre los seres procariotas y eucariotas. En 1904 en su Die Lebenswunder (Las maravillas de la vida), agrupa a las algas verdeazuladas (hasta entonces consideradas como vegetales) junto a las bacterias dentro de Moneres.
-
Empezó el estudio de las bacterias, las cuales serían la investigación central de su vida. Así fue como en 1872 descubrió que existen distintos tipos de microorganismos con formas y órganos diferentes, éstos los clasificó por ordenaciones sistemáticas.
-
Primero en aislar microorganismos. Descubrió el bacilo de la tuberculosis. Consistió en aislar el microorganismo causante de esta enfermedad y haerlo crecer en un cultivo puro, utilizando este cultivo para inducir la enfermedad en animales de laboratorio, en su caso la cobaya, aislando de nuevo el germen de los animales enfermos para verificar su identidad comparándolo con el germen original.
-
Pasteur demuestra que los hongos de los vinos, siempre presentes, son los causantes de la fermentación acética, responsable de malograr la formación y conservación del vino. Señala que si se calienta el vino durante un minuto con la botella cerrada (69-75°C), se evita su descomposición. Crea ENTONCES EL PROCESO DE PASTEURIZACION, que constituye una base fundamental de la preparación d
-
Aplicó la esterilización por calentamiento discontinuo, que actualmente se conoce tydalización, evidenció la existencia de formas microbacterianas por reposo, muy resistentes al calor. acias a esta demostración se le reconoce como padre de la Microbiología junto a Pasteur. La teoría derribó la anterior, de Generación Espontánea que se encontró vigente desde 1745.
-
Su teoría es que las células tienen en su superficie miléculas receptoras especifícas (cadenas laterales) qure sólo se unen a determinados grupos químicos de las moléculas de toxina; si las células sobreviven a esta unión, se produce un excedente de cadenas laterales, algunas de las cuales son liberadas a la sangre en forma de antitoxinas circulantes(lo que hoy llamamos anticuerpos).
-
Carlos Finlay observa que la fiebre amarilla es transmitida por mosquitos.La fiebre amarilla, o vómito negro (también llamada la plaga americana), es una enfermedad viral aguda e infecciosa causada por "el virus de la fiebre amarilla", que pertenece a la familia de los Flaviviridae, y del género Flavivirus amaril.3 Es una causa importante de enfermedad hemorrágica en muchos países de África y la zona norte de Sudamérica que origina 30 000 muertes cada año.
-
En 1881, Walther Hesse, esposo de Angelina Fannie se dio cuenta que la gelatina y budines que hizo a su esposa no se derretían a temperatura elevada, preguntándole a Fannie a que se debía y ella le comenta que empleó agar para su preparación. Gracias a ello Hesse sugirió el agar como una sustancia ideal para medio de cultivo, por sus usos en la cocina de su esposa.
-
Es conocido por descubrir la quimioautotrofia, el proceso por el cual los organismos derivan energia de un número de compuestos diferentes inorgánicos, obteniendo carbono en la forma de dióxido de carbono.La columna de Winogradski permite una fascinante observación de la ecologia de la quimioautotrofia y de los microbios.
-
Según el método de Paul Ehrlich, utilizando una solución de anilinay violeta de genciana, despues un tratamiento con lugol (iodo en yoduro potásico acuoso) y etanol observó que algunas bacterias retenían el colorante (por ejemplo los neumococos) mientras qye otras no lo hacian.Esto permitió dividir las bacterias en Gram- positivas y en Gram- negativas, clasificación que es de gran utilidad hoy día para elegir un tratamiento antibiótico.
-
Louis Pasteur puso a punto una vacuna contra la rabia.
La rabia o hidrofobia es una enfermedad aguda infecciosa viral del sistema nervioso central ocasionada por un Rhabdoviridae que causa encefalitis aguda con una letalidad cercana al 100 %. Es la zoonosis viral conocida más antigua. -
Escherich descubre Escherichia coli.La Escherichia coli también conocida por la abreviación de su nombre, E. coli, es quizás el organismo procariota más estudiado por el ser humano. Se trata de una enterobacteria que se encuentra generalmente en los intestinos animales, y por ende en las aguas negras, pero se lo puede encontrar en multitud de ambientes, dado que es un organismo ubicuo.
-
Confirmó la teoría de biogénesis, formulada por Louis Pasteur en 1864, aplicando esterilización por calentamiento discontinuo, que actualmente se conoce tyndalización, evidenció la existencia de formas microbacterianas por reposo, muy resistentes al calor, lo cual fue confirmado más tarde por Ferdinand Cohn. Gracias a esta demostración se le reconoce como padre de la Microbiología junto a Pasteur.
-
Richard Petri introduce el uso de las placas Petri en Microbiología.es un recipiente redondo, de cristal o plástico, con una cubierta de la misma forma que la placa, pero algo más grande de diámetro, para que se pueda colocar encima y cerrar el recipiente, aunque no de forma hermética. Es parte de la colección conocida como «material de vidrio». Se utiliza en Microbiología para cultivar células, observar la germinación de las semillas o examinar el comportamiento de pequeños animales.
-
Sergei Winogradsky.Los organismos quimiótrofos o quimiosintéticos son aquellos capaces de utilizar compuestos inorgánicos reducidos como sustratos para obtener energía y utilizarla en el metabolismo respiratorio. Es una facultad conocida con el nombre de quimiosíntesis
-
Los sueros son diferentes de las vacunas porque éstas confieren una inmunidad activa, es decir una capacidad para luchar contra el microbio, mientras que los sueros sólo brindan una inmunidad pasiva, una ayuda exterior contra el veneno segregado por el microbio. También son sueros los que se elaboran, por ejemplo, contra las picaduras de las víbora.
-
Fue el primer cientifico en descubrir los virus en 1892, al estudiar el llamdado virus del mosaico del tabaco. es un virus ARN que infecta plantas, especialmente al tabaco y a otros miembros de la familia Solanaceae. La infección produce manchas características en las hojas (de ahí su nombre).
-
Descubre sustancias en el nucleo de las celulas que hoy sabemos que son el ADN. son grandes polímeros formados por la repetición de monómeros denominados nucleótidos, unidos mediante enlaces fosfodiéster. Se forman, largas cadenas; algunas moléculas de ácidos nucleicos llegan a alcanzar tamaños gigantescos, con millones de nucleótidos encadenados.
-
Se interesaba en la microbiología aplicada a la agricultura y las industrias.Es considerado uno de los fundadores de la virología, y demostró, empleando filtros extremadamente finos, que el agente patógeno responsable de la enfermedad del mosaico del tabaco es mucho más pequeño que una bacteria. Él los nombra virus.
-
Descubrio y describió la importancia del vector biologico a través de la teoria metaxénica de la transmisión de enfermedades por agentes biológicos.niciativa de Finlay creó una Comisión Cubana de la Fiebre Amarilla que, siguiendo las indicaciones del médico cubano, combatió al mosquito y aisló a los enfermos. En sólo siete meses había desaparecido la enfermedad de Cuba.
-
Martinus Beijerinck. Método de enriquecimiento de cultivos. es un medio de cultivo que contiene los nutrientes necesarios para apoyar el crecimiento de una amplia variedad de microorganismos, entre ellos algunos de los más exigentes. Se utilizan comúnmente para la cosecha de diferentes tipos de microbios que están presentes en la muestra.
-
Paul Ehrlich descubre el salvarsán (balas mágicas), primer agente quimioterapéutico contra la sífilis.Este compuesto sintético resultó ser eficaz, curando la enfermedad y sin ser tóxico para el paciente. Gracias a este descubrimiento le concedieron el Premio Nobel en 1908. Hoy en día ya no se utiliza salvarsán para tratar la sífilis ya que ha sido reemplazado por un producto mucho más efectivo, el antibiótico penicilina.
-
Frederick Griffith lleva a cabo el descubrimiento de la transformación bacteriana.Griffith descubrió que una cepa no-virulenta (sin cápside) de Streptococcus pneumoniae podía ser transformada en virulenta (con cápsula) al exponerla a cepas virulentas que habían sido matadas con calor. En 1944, se demostró que este principio transformante era de índole genética, cuando Oswald Avery, Colin McLeod y Maclyn McCarty demostraron la transferencia génica en S. pneumoniae.
-
Alexander Fleming aísla la penicilina de un cultivo de Penicillium notatum.Además de sus propiedades antibacterianas, la penicilina es un efectivo antídoto contra los efectos del envenenamiento por α-amanitina, uno de los aminoácidos tóxicos de los hongos del género Amanita.
-
Helmut Ruska inventa el microscopio electrónico. Un microscopio electrónico es aquél que utiliza electrones en lugar de fotones o luz visible para formar imágenes de objetos diminutos. Los microscopios electrónicos permiten alcanzar amplificaciones mayores antes que los mejores microscopios ópticos, debido a que la longitud de onda de los electrones es mucho menor que la de los fotones "visibles".
-
Fue un fisico neerlandes ganador del premio Noble de fisica en 1953 por su invencion del microscopio de contraste de fases. s permite observar células sin colorear y resulta especialmente útil para células vivas. Este aprovecha las pequeñas diferencias de los índices de refracción en las distintas partes de una célula y en distintas partes de una muestra de tejido.
-
Domagk descubre las sulfamidas, el primer agente quimioterapeútico.es una sustancia química sintética derivada de la sulfonamida, bacteriostática y de amplio espectro. Las sulfamidas se emplean como antibióticos, antiparasitarios y coccidiostáticos en el tratamiento de enfermedades infecciosas. Las sulfas son usadas tanto en medicina humana, como el sulfametoxazol, la sulfadiazina y la sulfabenzamida, así como veterinaria, como el sulfanitrato, el sulfapirazol y la sulfaquinoxalina.
-
Publicó con Salvador Luria, un artículo en el que se enunciaba una ecuación que describia la relación de mutación en cultivos de bacterias, entre las susceptibles al virus y las resistentes.
-
El ADN ( ácido desoxirribonucleico) es el material del que los genes y los cromosomas están formados y de cómo estos definen la sexualidad del ser humano. Anteriormente se creía que eran las proteínas las portadoras de los genes.
-
Transducción Generalizada. Norton Zinder y Joshua Lederberg descubren el fenómeno de la transducción generalizada. Ocurre durante el ciclo lítico (ciclo donde el fago rompe la bacteria) de los fagos y es capaz de transferir cualquier parte del genoma bacteriano. Durante la fase de ensamblaje viral, fragmentos del cromosoma bacteriano pueden quedar en la cápsida viral. Cuando este fago infecta a una nueva bacteria, el material puede ser transferido al cromosoma bacterial.
-
La estructura de la molécula en doble hélice que es el ADN dio al mundo la llave para entender todos los secretos de la vida: toda la vida en la tierra existe únicamente gracias a este omnipresente ADN, desde la bacteria más pequeña hasta el hombre.
-
- Marshall Nirenberg y H. Gobind Khorana. Descubrimiento del código genético. es el conjunto de reglas que define traducir una secuencia de nucleótidos en el ARN a una secuencia de aminoácidos en una proteína, en todos los seres vivos, lo cual demuestra que ha tenido un origen único o universal, al menos en el contexto de nuestro planeta.
-
Su principal aporte a los estudios científicos fue la propuesta de clasificación taxonómica de los seres vivos en cinco reinos. Animalia, Plantae, Fungi, Protista y el actualmente obsoleto reino monera.
-
Basada en la comparación entre especies de la llamada secuencia del ARN ribosomal16s y 18s que comparten todos los seres vivos del planeta y que apenas ha sufrido cambios desde la aparición en la Tierra de las primeras formas de vida microbiológicas; Sus análisis filogenéticos en 1977 lo llevaron al descubrimiento de un nuevo dominio. Archaea.
-
Woese y George E. Fox reconocen las archeas como el tercer dominio de los seres vivos.son un grupo de microorganismos unicelulares que al igual que las bacterias, son de morfología procariota (sin núcleo ni, en general, orgánulos membranosos internos), pero que son fundamentalmente diferentes a éstas, de tal manera que conforman su propio dominio o reino.
-
Robert W. Holley aísla los tRNA, moléculas que incorporan los aminoácidos activados en las proteínas.
La enzima peptidil transferasa es una ribozima aminoacil transferasa (con número EC 2.3.2.12) que realiza la función esencial de los ribosomas. Se encarga de la formación de enlaces peptídicos entre aminoácidos adyacentes durante la traducción de ARN mensajero y, por tanto, la síntesis proteica. -
Ecología microbiana molecular.es la rama de la ecología que estudia a los microorganismos en su ambiente natural, los cuales mantienen una actividad continua imprescindible para la vida en la Tierra. Los mecanismos que mantienen la diversidad microbiana de la biosfera son la base de la dinámica de los ecosistemas terrestres, acuáticos y aéreos. Es decir, la base de la existencia de las selvas y de los sistemas agrícolas, entre otros.
-
Descubren Epulopiscium fishelsoni, la mayor célula procariota.Son células sin núcleo, la zona de la célula, donde está el ADN y ARN no está limitado por membrana. Ej. Bacteria. Actualmente están divididas en dos grupos:Eubacterias, que poseen paredes celulares formadas por peptidoglicano o por mureína.
-
La comunidad cientifica consideró a Stanley Prusiner un hereje, por defender la existencia de un nuevo agente infeccioso; el prión, una proteina sin material genético,causante, entre otras enfermedades, del [mal de las vacas locas] y su variante humana,la enfermedad de creutzfeldt- Jakob
-
2007 - se secuencia el genoma del Saccharopolyspora erythraea, el microorganismo productor del antibiótico eritromicina.El genoma secuenciado de la Saccharopolyspora erythraea comprende 8.212.805 pares de bases, las cuales codifican 7264 genes. El genoma es circular, como el de los Actinomycetales patógenos Mycobacterium tuberculosis y Corynebacterium diphtheriae, a diferencia de los cromosomas lineales del Streptomyces coelicolor A3 y el estrechamente relacionado Streptomyces avermitilis.
Plan projects on a visual timeline
Map milestones, phases, deadlines, and key events in one place so the sequence is easier to see and share. Timetoast is a timeline maker for work, school, research, and stories.